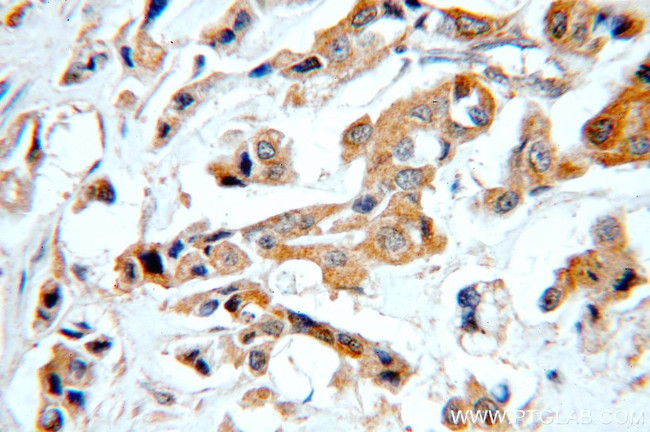
STAT2 Antibody in Immunohistochemistry (Paraffin) (IHC (P))
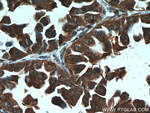
STAT2 Antibody in Immunohistochemistry (Paraffin) (IHC (P))

Search
Proteintech
STAT2 Polyclonal Antibody
{{$productOrderCtrl.translations['antibody.pdp.commerceCard.promotion.promotions']}}
{{$productOrderCtrl.translations['antibody.pdp.commerceCard.promotion.viewpromo']}}
{{$productOrderCtrl.translations['antibody.pdp.commerceCard.promotion.promocode']}}: {{promo.promoCode}} {{promo.promoTitle}} {{promo.promoDescription}}. {{$productOrderCtrl.translations['antibody.pdp.commerceCard.promotion.learnmore']}}
产品信息
51075-2-AP
种属反应
宿主/亚型
分类
类型
抗原
偶联物
形式
浓度
规格
纯化类型
保存液
内含物
保存条件
运输条件
产品详细信息
This antibody is a rabbit polyclonal antibody raised against a peptide mapping within human STAT2. The calculated molecular weight of STAT2 is 98 kDa, but phosphorylated STAT2 is about 100-113 kDa.
靶标信息
STAT2 is a member of the STAT protein family. In response to cytokines and growth factors, STAT family members are phosphorylated by the receptor associated kinases, and then form homo- or heterodimers that translocate to the cell nucleus where they act as transcription activators. In response to interferon (IFN), this protein forms a complex with STAT1 and IFN regulatory factor family protein p48 (ISGF3G), in which this protein acts as a transactivator, but lacks the ability to bind DNA directly. Transcription adaptor P300/CBP (EP300/CREBBP) has been shown to interact specifically with this protein, which is thought to be involved in the process of blocking IFN-alpha response by adenovirus.
仅用于科研。不用于诊断过程。未经明确授权不得转售。
生物信息学
蛋白别名: interferon alpha induced transcriptional activator; MGC59816; p113; Signal transducer and activator of transcription 2; signal transducer and activator of transcription 2, 113kDa; STAT; STAT 2; STAT-2; unnamed protein product
基因别名: IMD44; ISGF-3; P113; PTORCH3; STAT113; STAT2
UniProt ID: (Human) P52630
Entrez Gene ID: (Human) 6773